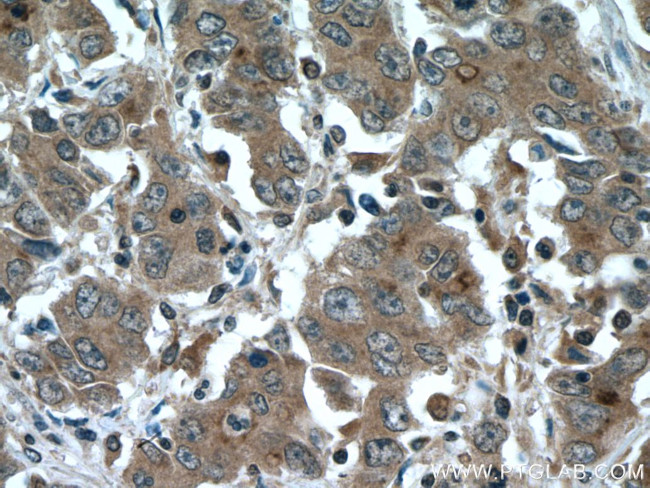
IQGAP3 Antibody in Immunohistochemistry (Paraffin) (IHC (P))

Search
Proteintech
IQGAP3 Polyclonal Antibody
{{$productOrderCtrl.translations['antibody.pdp.commerceCard.promotion.promotions']}}
{{$productOrderCtrl.translations['antibody.pdp.commerceCard.promotion.viewpromo']}}
{{$productOrderCtrl.translations['antibody.pdp.commerceCard.promotion.promocode']}}: {{promo.promoCode}} {{promo.promoTitle}} {{promo.promoDescription}}. {{$productOrderCtrl.translations['antibody.pdp.commerceCard.promotion.learnmore']}}
产品信息
25930-1-AP
种属反应
宿主/亚型
分类
类型
抗原
偶联物
形式
浓度
规格
纯化类型
保存液
内含物
保存条件
运输条件
产品详细信息
Immunogen sequence: LINEALDKG SPEKTLSALL LPAAGLDDVS LPVAPRYHLL LVAAKRQKAQ VTGDPGAVLW LEEIRQGVVR ANQDTNTAQR MALGVAAINQ AIKEGKAAQT ERVLRNPAVA LRGVVPDCAN GYQRALESAM AKKQCPADTA FWVQHDMKDG TAYYFHLQTF QGIWEQPPGC PLNTSHLTRE EIQSAVTKVT AAYDRQQLWK ANVGFVIQLQ ARLRGFLVRQ KFAEHSHFLR TWLPAVIKIQ AHWRGYRQRK IYLEWLQYFK ANLDAIIKIQ AWARMWAARR QYLRRLHYFQ KNVNSIVKIQ AFFRARKAQD DYRILVHAPH PPLSVVRRFA HLLNQSQQDF LAEAELLKLQ EE (530-880 aa encoded by BC131536)
靶标信息
IQGAP3 (IQ motif containing GTPase activating protein 3) is a 1,631 amino acid protein that acts as an effector of Cdc42 and Rac 1, linking their activation to the cytoskeleton during neuronal morphogenesis. A novel member of the IQGAP family, IQGAP3 is highly expressed in brain where it localizes to axons of hippocampal neurons. IQGAP3 contains one Ras-GAP domain, a CH (calponin-homology) domain, four IQ domains and is encoded by a gene located on human chromosome 1, which spans 260 million base pairs, contains over 3,000 genes and comprises nearly 8% of the human genome. Chromosome 1 houses a large number of disease-associated genes, including those that are involved in familial adenomatous polyposis, Stickler syndrome, Parkinson's disease, Gaucher disease, schizophrenia and Usher syndrome. Aberrations in chromosome 1 are found in a variety of cancers, including head and neck cancer, malignant melanoma and multiple myeloma.
仅用于科研。不用于诊断过程。未经明确授权不得转售。
生物信息学
蛋白别名: IQGA3; IQGAP3; MGC10170; Ras GTPase-activating-like protein IQGAP3; unnamed protein product
基因别名: IQGAP3
UniProt ID: (Human) Q86VI3
Entrez Gene ID: (Human) 128239